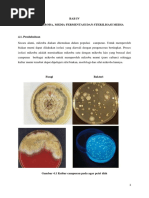

0% menganggap dokumen ini bermanfaat (0 suara)
126 tayangan9 halamanIsolasi dan Regenerasi Mikroorganisme
Praktikum isolasi dan regenerasi mikroorganisme bertujuan untuk menguasai teknik isolasi dan seleksi mikroorganisme. Dilakukan isolasi dari mix culture dengan metode pengenceran pada media agar Na dan GYEA. Hasil isolasi tahap pertama menunjukkan pertumbuhan bakteri pada agar Na dan ragi pada GYEA. Isolasi tahap kedua dilakukan untuk mendapatkan kultur yang lebih murni.
Diunggah oleh
aryaHak Cipta
© © All Rights Reserved
Kami menangani hak cipta konten dengan serius. Jika Anda merasa konten ini milik Anda, ajukan klaim di sini.
Format Tersedia
Unduh sebagai DOCX, PDF, TXT atau baca online di Scribd
0% menganggap dokumen ini bermanfaat (0 suara)
126 tayangan9 halamanIsolasi dan Regenerasi Mikroorganisme
Praktikum isolasi dan regenerasi mikroorganisme bertujuan untuk menguasai teknik isolasi dan seleksi mikroorganisme. Dilakukan isolasi dari mix culture dengan metode pengenceran pada media agar Na dan GYEA. Hasil isolasi tahap pertama menunjukkan pertumbuhan bakteri pada agar Na dan ragi pada GYEA. Isolasi tahap kedua dilakukan untuk mendapatkan kultur yang lebih murni.
Diunggah oleh
aryaHak Cipta
© © All Rights Reserved
Kami menangani hak cipta konten dengan serius. Jika Anda merasa konten ini milik Anda, ajukan klaim di sini.
Format Tersedia
Unduh sebagai DOCX, PDF, TXT atau baca online di Scribd